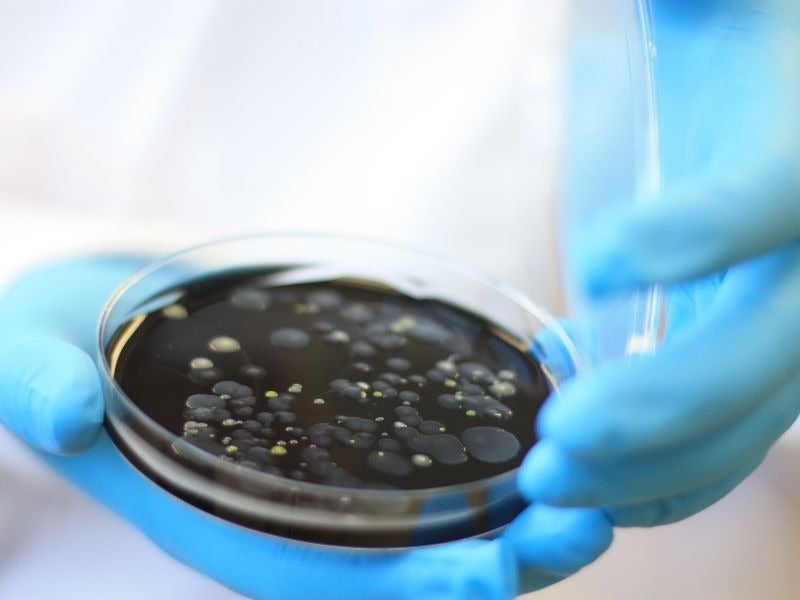

In the Western world, approximately 10 in every million people contract Legionnaires’ disease – a severe form of pneumonia caused by exposure to the Legionella pathogen – annually. Legionella is commonly found in water systems and is transferred to humans when water droplets containing the bacteria find their way into the respiratory tract.
In most cases, Legionnaires’ disease causes mild flu-like symptoms such as fever, headaches, muscle pain, and coughing. However, for the elderly, those with weakened immune systems, or smokers, exposure to the bacteria can prove fatal.

Discover B2B Marketing That Performs
Combine business intelligence and editorial excellence to reach engaged professionals across 36 leading media platforms.
The bacteria often thrives in systems where water is recycled, such as air conditioning systems and hot tubs.
According to SOCOTEC, the UK’s leading provider of testing, inspection, and compliance services, legionella is also likely to be present in most railway water systems, whether in depots, stations, cleaning and maintenance facilities, or onboard trains. The bacteria is usually only present at low levels, yet, given the risks, it still poses a significant health and safety concern that rail operators must take seriously.
The presence of Legionella on board trains
“Legionella can potentially thrive in any water systems,” Paul Sear, national technical manager, Water Hygiene, SOCOTEC UK, explains. “When SOCOTEC has sampled on behalf of its clients, our Water Hygiene team has found Legionella in many different environments, including domestic hot and cold water systems, tanking facilities, carriage wash machines, and on-board trains.”
“However, one particular area for concern would be carriage wash machines, especially where water is recycled,” Sear says.
These systems, usually installed at railway depots to wash and rinse carriages between uses, typically rely on recycled water. This helps to reduce the operator’s water consumption and, subsequently, its environmental impact. However, while these systems are commonly filtered to ensure the water used is clean, nutrients that allow the bacteria to grow are often left behind, providing an opportunity for Legionella to flourish and spread.
According to Sear, water storage tanks and tanking facilities found at depots, stations, and infrastructure buildings also pose an increased risk if they aren’t managed and treated appropriately.
This is particularly the case in the summer months, when static water inside the tank heats up, creating a breeding ground for Legionella – which is known to thrive when water temperature remains between 20°C and 45°C – to multiply.
A risk to railway workers and riders?
To date, there have been no reported cases of Legionnaires’ disease resulting directly from rail travel, but the potential for exposure, both to rail industry workers and the public, is there. In 2011, for example, testing carried out on 150 trains across the UK found that one in three onboard water systems contained the Legionella bacteria.
“Reasons [for the presence of Legionella] can include poor water temperature control, stagnation, and no chemical treatment in carriage wash machines,” Sear explains.
“While there is the potential for anyone who works within the railway industry to be exposed to Legionella bacteria, there is a considerably high risk to those who use water systems that are not appropriately managed to be exposed.”
“The risk to the public would most likely come from carriage wash machines if these systems are not suitably maintained and managed, and potentially from onboard water systems.”
A duty of care
According to the UK’s Health Protection Agency (HPA), the presence of Legionella in railway water systems presents little risk to the general population, but with the potential health implications of Legionella in mind, rail operators have a duty of care to minimise any potential risk to their workers and passengers.
In the UK, Legionella management and control comes under health and safety regulations, Sear explains. This means that, under the Health and Safety at Work Act 1974 (HSWA 1974) and Control of Substances Hazardous to Health 2002 (COSHH), rail companies have a duty to protect their employees and members of the public from harm. Breach of health and safety regulations is a criminal offence, and is punishable by imprisonment of up to two years and an unlimited fine.
The Health and Safety Executive (HSE), the government agency responsible for encouraging, regulating, and enforcing workplace health, safety, and welfare, has also published a separate code of practice titled The Control of Legionella Bacteria in Water Systems – L8. This provides those responsible for controlling the presence of legionella in water systems with guidelines on how to identify, assess, manage, and control sources of risk.
“This document has special legal status and outlines the requirements of those in control of premises on how to manage the risk. It is supported by HSG274 Parts 1-3 [Legionnaires’ disease: Technical guidance], which provides guidance on managing the risk in the different types of water systems such as hot and cold water systems, evaporative cooling systems and carriage wash machines,” Sear explains.
Legionella on board trains: areas for improvement
Generally, there is a “good proactive approach” to Legionella control in the rail industry. SOCOTEC works with various organisations across the railway industry, providing risk assessments, monitoring, training and bacterial sampling services that help to ensure compliance with the necessary health and safety regulations.
However, “there are always areas for improvement, especially as Legionella management and control is an ongoing daily and weekly challenge”, Sear says.
According to SOCOTEC, rail companies must ensure that they have up-to-date, suitable and sufficient risk assessment, a written scheme of control, and appropriate control measures, as well as responsible and deputy responsible persons appointed to manage the risk of Legionella in the company’s water systems.
“It is all about having sufficient and proportional management of the risk,” Sear adds.





